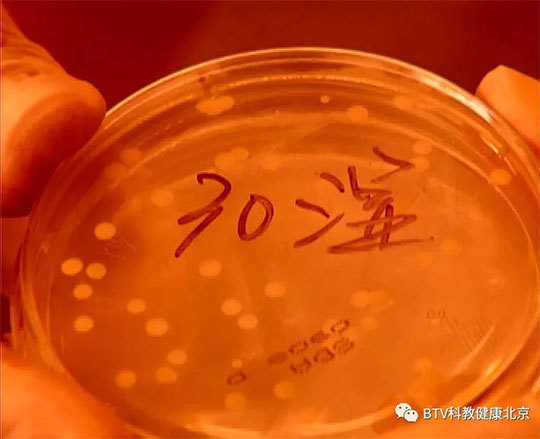
《健康北京》口角开裂查查牙

指导意见:你好,根据你的情况所描述考虑可能是首先要多喝水,可以做一些是常的护理.唇部干燥可以用甘油或是橄榄油涂抹,也可以用眼霜涂抹嘴唇,效果不错。
口角炎,俗称烂嘴角,常发生在口角黏膜的一侧或两侧。因病因不同而分为营养不良性口角炎、球菌性口角炎、真菌性口角炎。营养不良性口角炎在营养缺乏和维生素B族缺乏者
病情分析: 意见建议:补充些维生素A,多吃新鲜蔬菜、水果,保证维生素充足。 已经开裂的地方涂些润肤保湿的油膏,凡士林、甘油等,多注意,很快会好的。
口角开裂俗称烂嘴角,常发生在口角黏膜的一侧或两侧。因病因不同而分为营养不良性口角炎、球菌性口角炎、真菌性口角炎。营养不良性口角炎在营养缺乏和维生素B族缺乏者中常有发生,以维生素B族缺乏引起的口角炎最常见。最初表现为口角上发红、发痒,接着上皮脱落,形成糜烂、浸渍或裂痕,张嘴时拉裂而易出血,吃饭说话等都受到影响。此病并非是人们所说"上火"。 特别是孩子饮食搭配不好或有偏食习惯,或在慢性腹泻痢疾时易发生。冬天易得此病,是因为冬季气候比较干燥,蔬菜、水果相对吃得少些,常有维生素C和B2的缺乏,引起口角开裂后,人们就喜欢用舌头去舐它,目的是想使嘴唇和口角区潮润些,可以得到一时的舒服。然而唾液碰到干燥空气很快地被蒸发,这样不但不能解决干燥的问题,相反会唾液中的微生物带至裂口中,引起细菌感染,加重口角的炎症。 出现口角开裂 ,可用些油脂或防裂油涂在上面,可服用维生素B2,每日3次,每次1-2片,局部可涂用冰硼散或云南白药。 口角开裂如已经糜烂发炎,可用1%的龙胆紫药水在口角上每日涂布两次。经过这些简单的治疗,绝大多数口角炎能很快治愈。
嘴唇开裂的原因有很多种,除了天气干燥,身体内缺失水分,还有上火,体内缺乏维生素等原因引起的,一味的补水反而会增加肾脏的负担。嘴唇开裂出血实际是患上了口角炎,口角炎
口角裂开了怎么办? 健康分享者:小铃铛1158 更新时间:2013-10-23 15:36:02 概述 秋冬季节容易出现嘴角干裂、开口现象,这就是我们常说的秋燥现象,那么秋季通过什么方法能
简介:口角炎(angular cheilitis)是不同因素所致的口角部位的皮肤及其临近黏膜的急性或慢性炎症。主要在儿童间流
嘴唇开裂的原因有很多种,除了天气干燥,身体内缺失水分,还有上火,体内缺乏维生素等原因引起的,一味的补水反而会增加肾脏的负担。嘴唇开裂出血
病情分析: 您好!根据您的描述,口角开裂已很久了,属于缺乏维生素B2引起的症状,症状表现为:口角处发生湿白、糜烂、皲裂现象,如果出现口角干裂、发痒的症状,不
您好,口服抗病毒药物如阿昔洛韦片试试。

【图】嘴角开裂怎么治? 分享防治嘴角开裂食谱
500x350 - 20KB - JPEG

口角开裂 用它就能搞定了(2) - 三九养生堂
400x294 - 15KB - JPEG

《健康北京》口角开裂查查牙
540x439 - 35KB - JPEG
《健康北京》口角开裂查查牙
540x439 - 36KB - JPEG

口角溃疡图片
324x201 - 8KB - JPEG

《健康北京》口角开裂查查牙
540x438 - 40KB - JPEG

大突破】西安整形医院价格表分类详细 口角成
393x246 - 33KB - JPEG

口唇疱疹 去病毒 烂唇 口唇脱皮开裂性唇炎 口角
460x460 - 98KB - JPEG
养兔经验:垂耳兔口角炎初期症状,垂耳兔长口角
500x500 - 26KB - JPEG
养兔经验:垂耳兔口角炎初期症状,垂耳兔长口角
500x280 - 46KB - JPEG

【有病不愁】韩国jk整容医院官网 淄博权威整容
597x374 - 49KB - JPEG

口腔执业医师实践技能第三站(病史采集)辅导精
993x1404 - 248KB - PNG

【今日头条】厦门自体脂肪隆鼻 西京医院美容
555x347 - 40KB - JPEG

【阴虚阳亢】上海去眼袋 去除手部皱纹比较好
565x354 - 46KB - JPEG

【自然疗法】泉州丰胸哪家好 韩国美泊门整形
562x352 - 46KB - JPEG